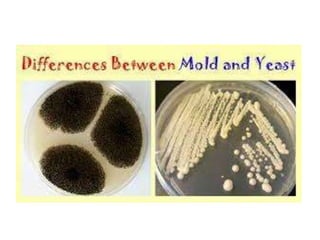

Fungi are eukaryotic organisms that can exist as unicellular yeasts or multicellular molds and mushrooms. They have rigid cell walls made of chitin and reproduce both sexually through spores and asexually through budding or fragmentation. Yeasts are unicellular while molds are filamentous and made up of branching hyphae. Fungi play important roles in industries like food production as well as in biodegradation and antibiotic production. Medically important fungi are classified into four divisions: Ascomycetes, Basidiomycetes, Zygomycetes, and Deuteromycetes.